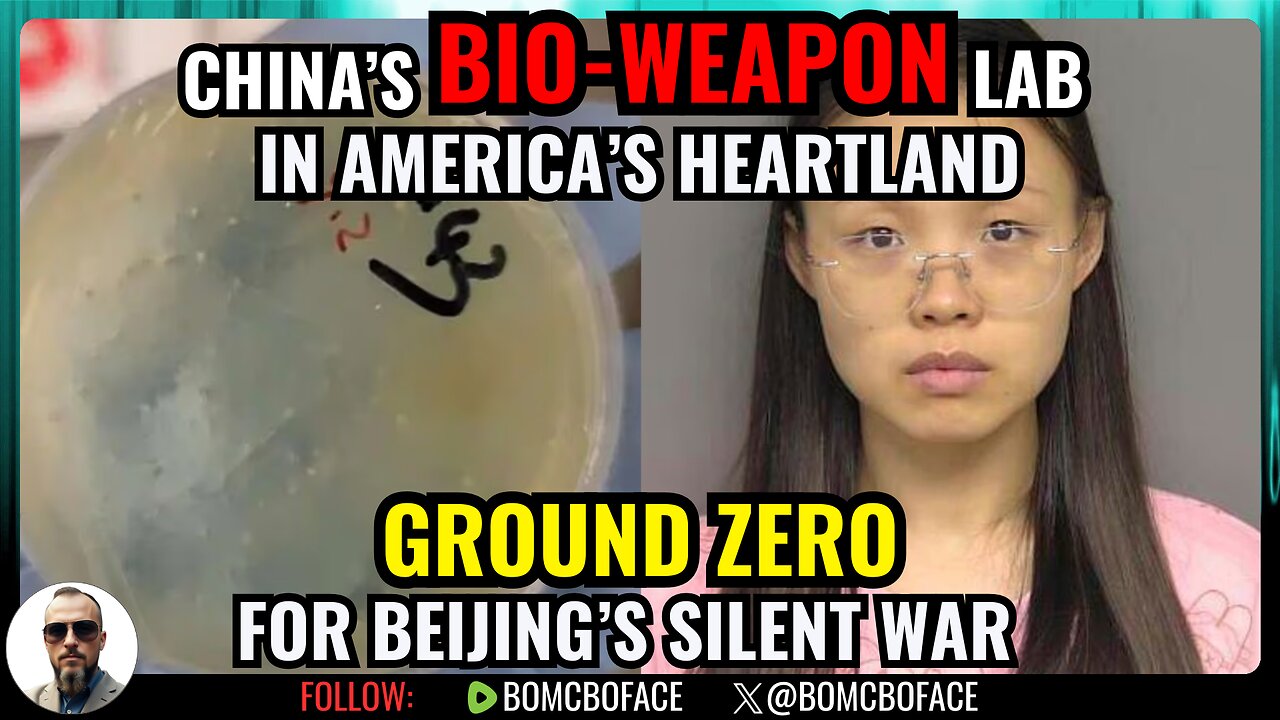
UK Jails Dad for HATE TUNES, China's Bio-Weapon in MI, Hegseth Turtle Meme Crime | Bo McBoface LIVE

Premium Only Content
This video is only available to Rumble Premium subscribers. Subscribe to
enjoy exclusive content and ad-free viewing.
UK Jails Dad for HATE TUNES, China's Bio-Weapon in MI, Hegseth Turtle Meme Crime | Bo McBoface LIVE
Streamed on:
40
UK jails a dad 3 yrs for music. China turned Michigan’s Big House into a bio-weapons lab. Hegseth’s Franklin the Turtle meme triggers “war crimes” meltdowns.
Illegal trucker kills Americans. Keith Ellison & Walz fraud tapes. Trump fires judges & defends boat strikes in today’s Cabinet.
Streaming LIVE on Rumble and X at 6 PM EST!
Please Follow the channel, Smash that Like button, and share the show with your friends!
💬 Sound off in chat! Bo reads YOUR takes live.
Follow @BoMcBoface on X for updates and memes.
Watch Bo live every Tuesday & Thursday 6–8PM EST for more unfiltered truth.
Sources:
Loading 1 comment...
-
 15:38
15:38
Bo McBoface
14 days ago49-Time Felon Screams “BURN B*TCH!” As He Sets Woman on Fire on Chicago Train | Bo McBoface LIVE
39 -
![Mr & Mrs X - [DS] Pushing Division, Traitors Will Be Exposed, Hold The Line - EP 18](https://1a-1791.com/video/fwe2/96/s8/1/w/U/W/F/wUWFz.0kob-small-Mr-and-Mrs-X-DS-Pushing-Div.jpg) 54:40
54:40
X22 Report
3 hours agoMr & Mrs X - [DS] Pushing Division, Traitors Will Be Exposed, Hold The Line - EP 18
78.9K11 -
 LIVE
LIVE
LumpyPotatoX2
28 minutes agoDestiny Rising: Gameplay - Partnered Creator
450 watching -
 1:10:32
1:10:32
Wendy Bell Radio
6 hours agoPet Talk With The Pet Doc
20K15 -
 LIVE
LIVE
ttvglamourx
25 minutes agoHAPPY SATURDAY !DISCORD
198 watching -
 18:53
18:53
Wrestling Flashback
23 days ago $7.88 earned10 WWE Wrestlers Who Ruined Their Bodies Wrestling Too Long
14.1K4 -
 LIVE
LIVE
Amarok_X
1 hour ago🟢LIVE ARC RAIDERS | TOPSIDE FOR SCRAPPY | PREMIUM CREATOR | VETERAN GAMER
190 watching -
 27:03
27:03
The Kevin Trudeau Show Limitless
3 days agoThey're Not Hiding Aliens. They're Hiding This.
49.4K72 -
 22:17
22:17
MetatronGaming
6 days agoI spent 7 days in the 1980s
10K5 -
 LIVE
LIVE
FrizzleMcDizzle
1 hour agoGRINDING new NightReign content - COME HANG
112 watching